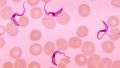

破・常識 あつしの歴史ブログ「アシュタール:これが満たされた状態」
今日の破・常識!
一時的な高揚感のご機嫌ではなく
いつも満たされた状態にいてくださいということです。
好きなことを好きなときに好きなだけする・・
これが満たされた状態のご機嫌さんなのです。byアシュタール
アシュタールからのメッセージ
今日のアシュタールからのメッセージをお伝えします。
「これが満たされた状態」by アシュタール
「こんにちは こうしてお話しできることに感謝します。
ご機嫌さんでいてください。
ご機嫌さんというのは満たされた状態のことです。
何かの刺激によって”ヒャッハ~”となる事ではありません。
何かの刺激によってご機嫌な気分になることはありますが
それは長く続きません。
なぜならば刺激による高揚感だからです。
それは私がお伝えしているご機嫌さんではないのです。
ご機嫌さんは満たされた状態です。
ですから高揚感はありません。
ただ満たされているという状態を感じるだけなのです。
刺激を求めている方には何か物足りなさを
感じるかもしれませんね。
我慢しないことで欲求不満にならない状態になります。
イヤなことをしない、好きなことを好きなときに
好きなだけしていると満たされます。
人は満たされた状態にいると誰かに干渉したいと思わなくなります。
それは何故でしょうか?
自分が満たされていると寛容になれるからです。
寛容になるというのは、何かを許可するとか
上から目線で許すとかそういうことではなく
相手に対しての尊敬と感謝の気持ちが多くなるからです。
相手を尊重するということは、相手が何をしても
それはその人の自由だと思えるのです。
これをしてはいけない、これをするべきだ・・
という考えはなくなります。
それぞれの自由ですので、どうぞお好きになさってください
と思えるのです。
そして、自分も好きにしますと思えるので、誰かが干渉してきたら
それは止めてくださいと静かに伝えることが出来ます。
だから、ケンカということにならないのです。
それが住み分けるということなのです。
お互い好きなことをしましょうね・・これが住み分けです。
干渉しあうと住み分けることが出来ません。
対立などは干渉になりますので、住み分けではなく
同じ土俵に乗っているということになります。
ご機嫌さんでいたら波動が軽くなります
とお伝えしているのはそういうことなのです。
(波動が重い軽いは、良い悪いではありません)
それぞれの自由(相手の対する尊敬と感謝の気持ち)
が多くなると波動が軽くなるのです。
だから、何度も言いますが一時的な刺激による
ご機嫌な気持ちは波動が軽くなるご機嫌さんとは
違うということです。
誰かに勝ってご機嫌さん、何かの勝負に勝ってご機嫌さん・・
それは波動の軽くなるご機嫌さんではなく
一時的な刺激による高揚感なのです。
あなた達がそれぞれご機嫌さんな状態でいると
ケンカはなくなります。
そして、考え方が違う人たちと干渉し合わなくなります。
それは、考え方が違う人たちからそっと離れる、
住み分けるということなのです。
波動領域の違い・・という表現になると
難しく思ってしまうかもしれませんが
簡単に言うとお互いの意見を尊重し合うということだけなのです。
自分が相手に干渉しなくなると、相手も干渉できなくなります。
だから、住み分けることが出来るのです。
いまの重い社会からそっと離れるにはどうしたらいいですか?
それには何度もお伝えしているようにご機嫌さんの状態で
いてくださいとまたお伝えしたいと思います。
一時的な高揚感のご機嫌ではなく
いつも満たされた状態にいてくださいということです。
好きなことを好きなときに好きなだけする・・
これが満たされた状態のご機嫌さんなのです
あなたに愛をこめてお伝えいたします」
ありがとう、アシュタール!
マイコメント
自分の心が満たされてくると他人のことはあまり気にならなくなります。
それは自分の自由が満たされているからです。
そして、他人の自由に関しても干渉しなくなります。
そうなるとお互い風通しがよくなり互いに干渉しなくなるのでとても
いい関係が築けるようになります。
もちろん、不満解消のために時々は享楽という一時的な刺激を求めるのも
いいだろうと思います。
しかし、それは一時的に行うものであり心を満たすものではないので
誤解しないようにしましょう。

コメント